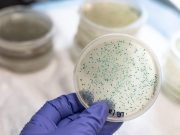
Regional Decolonization Aids Multidrug-Resistant Organism-Related Outcomes

Cyberattack Cripples Major U.S. Health Care Network
Sociodemographics Tied to Rehab Use During Critical Illness Hospitalization
Dual Medicare and Medicaid eligibility, rural residence linked to lower odds of physical, occupational therapy receipt
Personalized Tool Can Predict Infants at Increased Risk for RSV
Tool included 19 variables and had good predictive accuracy, identifying those who did not qualify for palivizumab
Two-Thirds of Survivors of the Most Severe COVID-19 Face Impairment at One Year
Physical, psychiatric, and cognitive problems seen in those discharged to long-term acute care hospitals
RSV Burden in Children Under 5 Increased in 2021 and 2022 Versus 2015-2019
Children aged 24 to 59 months were 4.86 times as likely to be hospitalized in 2022 versus 2015 to 2019
FDA Approves New Antibiotic for Three Indications
Zevtera approved for S. aureus bloodstream infections, acute bacterial skin/skin structure infections, and bacterial pneumonia
Disease Severity Similar for RSV as Unvaccinated COVID-19, Influenza
Odds of invasive mechanical ventilation, death significantly increased for those with RSV versus vaccinated COVID, flu
Guidance Lacking for Inpatient Management of Asymptomatic HTN
Inconsistent recommendations found for managing hypertensive urgencies, but outpatient BP goals were clearly defined
Screening Tool Can Streamline Palliative Care Consults in the ICU
Standardized method may speed up consultations by as much as six days
Regional Decolonization Aids Multidrug-Resistant Organism-Related Outcomes
Benefits include lower carriage, infections, hospitalizations, costs, and deaths